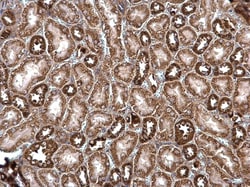
Invitrogen ROCK2 Polyclonal Antibody 100 &mu;L; Unconjugated:Antibodies,

Learn More
Invitrogen™ ROCK2 Polyclonal Antibody


Rabbit Polyclonal Antibody
Brand: Invitrogen™ PA578290
Description
Positive Control: 293T, A431, HeLa, HepG2, Rat2, Neuro 2A, GL261, C8D30, NIH-3T3, BCL-1, Raw264.7, C2C12, A549, H1299, HCT116 Predicted Reactivity: Xenopus laevis (80%), Rhesus Monkey (100%), Bovine (97%) Store product as a concentrated solution. Centrifuge briefly prior to opening the vial.
ROCK2, the predominant ROCK isoform in skeletal muscle, is an important regulator downstream of Rho GTPases. ROCK2 regulates cytokinesis, smooth muscle contraction, the formation of actin stress fibers and focal adhesions, and the activation of the c-fos serum response element. This protein, which is an isozyme of ROCK1 is a target for the small GTPase Rho.
Specifications
| ROCK2 | |
| Polyclonal | |
| Unconjugated | |
| ROCK2 | |
| B230113H15Rik; KIAA0619; mKIAA0619; p150 ROK-alpha; p164 ROCK-2; Rho associated coiled-coil containing protein kinase 2; Rho kinase 2; RhoA - binding serine/threosine kinase alpha (ROK - alpha); rhoA-binding kinase 2; Rho-associated coiled-coil containing protein kinase 2; Rho-associated coiled-coil forming kinage 2; Rho-associated coiled-coil forming kinase 2; rho-associated protein kinase 2; Rho-associated, coiled-coil-containing protein kinase 2; rho-associated, coiled-coil-containing protein kinase II; Rho-kinase; ROCK II; Rock2; Rock2m; rockii; ROCK-II; ROK; ROKalpha | |
| Rabbit | |
| Antigen affinity chromatography | |
| RUO | |
| 19878, 25537, 9475 | |
| Store at 4°C short term. For long term storage, store at -20°C, avoiding freeze/thaw cycles. | |
| Liquid |
| Immunohistochemistry (Frozen), Immunohistochemistry (Paraffin), Immunoprecipitation, Western Blot, Immunocytochemistry | |
| 0.4 mg/mL | |
| PBS with 20% glycerol, 1% BSA and 0.025% ProClin 300; pH 7 | |
| O75116, P70336, Q62868 | |
| ROCK2 | |
| Recombinant protein encompassing a sequence within the center region of human ROCK2. The exact sequence is proprietary. | |
| 100 μL | |
| Primary | |
| Human, Mouse, Rat | |
| Antibody | |
| IgG |
Your input is important to us. Please complete this form to provide feedback related to the content on this product.